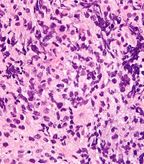

A dose-adjusted regimen of etoposide, doxorubicin, and cyclophosphamide with vincristine, prednisone, and rituximab (DA-EPOCH-R) obviated the need for radiotherapy in patients with primary mediastinal B-cell lymphoma in a single-group, phase II, prospective study.
A dose-adjusted regimen of etoposide, doxorubicin, and cyclophosphamide with vincristine, prednisone, and rituximab (DA-EPOCH-R) obviated the need for radiotherapy in patients with primary mediastinal B-cell lymphoma in a single-group, phase II, prospective study conducted by the National Cancer Institute (NCI), National Institutes of Health (NIH) in Bethesda, Maryland. Findings were reported April 11 in the New England Journal of Medicine.
Very high magnification micrograph of a primary mediastinal large B-cell lymphoma; Copyright © 2012
Nephron
No standard treatment exists for this subtype of diffuse large B-cell lymphoma, which occurs most often in young patients who present with large mediastinal masses. The inadequacy of immunochemotherapy alone has led to routine consolidation with mediastinal radiotherapy, which has potentially serious late effects. “We aimed to develop a strategy that improves the rate of cure and obviates the need for radiotherapy,” said Wyndham H. Wilson, MD, PhD, of the Center for Cancer Research. A previous study of DA-EPOCH produced an overall survival rate of 79%. The present study, said Wilson, was undertaken to test the hypothesis that the addition of rituximab may improve treatment.
Fifty-one patients with untreated primary mediastinal B-cell lymphoma were enrolled in the trial for treatment with DA-EPOCH-R and filgrastim without radiotherapy. Investigators used results from a retrospective study of DA-EPOCH-R from another center for independent verification of the outcomes. Median age of the patients was 30 years (range, 19–52); median tumor diameter was 11 cm. Thirty-one patients (59%) were women.
Patients received 6 to 8 cycles of chemotherapy consisting of DA-EPOCH-R with filgrastim. Disease sites were evaluated after cycles 4 and 6. Patients with a reduction of more than 20% in the greatest diameter of their tumor masses between cycles 4 and 6 received 8 cycles of treatment. Patients with a reduction of 20% or less between cycles 4 and 6 discontinued therapy after 6 cycles.
The event-free survival rate was 93% (95% confidence interval [CI], 81–98) during a median of 5 years follow-up, and the overall survival rate was 97% (95% CI, 81–99). No late morbidity or cardiac toxic effects were observed in any patient. After follow-up ranging from 10 months to 14 years, all but two of the 51 patients (4%) who received DA-EPOCH-R without radiotherapy were in complete remission. The other two patients received radiotherapy and were disease-free at follow-up.
The improvement in event-free and overall survival rates over those achieved previously with DA-EPOCH alone “suggests that the addition of rituximab may account for the improvement, and is consistent with other reports,” the investigators noted.
Use of neutrophil-based dose adjustment maximized dose delivery and limited incidences of fever and neutropenia to 13% of the cycles, the authors explained. The infusional schedule of doxorubicin allowed for delivery of high maximal and cumulative doses of doxorubicin without clinically significant cardiac toxicity. “These findings suggest that DA-EPOCH-R is a therapeutic advance for this type of lymphoma. Our results suggest that rituximab significantly improves the outcome of chemotherapy in patients with primary mediastinal B-cell lymphoma.”
The study was supported by the NCI. An international trial of DA-EPOCH-R in children with primary mediastinal B-cell lymphoma has already been initiated (ClinicalTrials.gov number, NCT01516567) to confirm the findings.